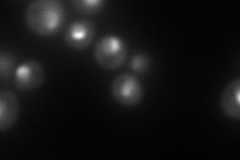
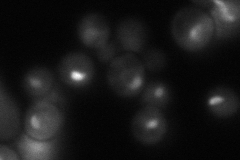
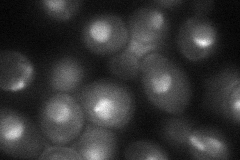

View description
Nucleolar protein involved in pre-rRNA processing; depletion causes severely decreased 18S rRNA levels
Localization:
Intensity:
Fold change:
Significance:
-
C’ GFP library in SD

below threshold17.57 -
N' NOP1pr-GFP in SD

nucleolus154.921 -
N' TEF2pr-mCherry in SD
nucleus,nucleolus173.045 -
N' NATIVEpr-GFP in SD
nucleolus77.658 -
N' TEF2pr-VC and Cyto-VN in SD
nucleus,nucleolus52.2571 -
C’ GFP library in SD+DTT

cytosol17.671No -
C’ GFP library in SD+H2O2

cytosol20.031.13No -
C’ GFP library in Starvation Media

cytosol15.660.89No -
C’ GFP library on the background of Pup2-DaMP

below threshold -
C’ GFP library on the background of CCT mutant

below threshold16.87650.959906No
